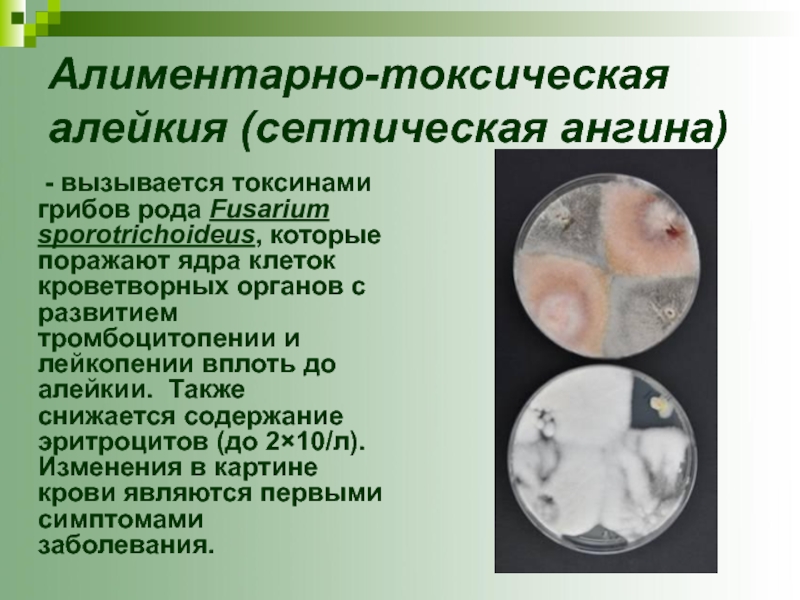

Разделы презентаций
- Разное
- Английский язык
- Астрономия
- Алгебра
- Биология
- География
- Геометрия
- Детские презентации
- Информатика
- История
- Литература
- Математика
- Медицина
- Менеджмент
- Музыка
- МХК
- Немецкий язык
- ОБЖ
- Обществознание
- Окружающий мир
- Педагогика
- Русский язык
- Технология
- Физика
- Философия
- Химия
- Шаблоны, картинки для презентаций
- Экология
- Экономика
- Юриспруденция
ПИЩЕВЫЕ ОТРАВЛЕНИЯ
Содержание
- 1. ПИЩЕВЫЕ ОТРАВЛЕНИЯ
- 2. Пищевые отравления – это преимущественно
- 3. Слайд 3
- 4. Слайд 4
- 5. Слайд 5
- 6. Слайд 6
- 7. Слайд 7
- 8. Пищевые отравления микробной природы - это
- 9. Пищевые отравления микробного происхождения имеют ряд особенностей:часто
- 10. По патогенезу микробные пищевые отравления разделяют на 3 группы: Токсикоинфекции Токсикозы Смешанной этиологии (миксты)
- 11. Пищевые токсикоинфекции (ПТИ) ПТИ —
- 12. Для возникновения заболевания необходимы благоприятные условия:содержание в
- 13. Широко распространена в природе,
- 14. На предприятиях общественного питания основным
- 15. Протей (Proteus vulgaris и Proteus mirabilis)
- 16. На предприятия может поступать сырье
- 17. Энтерококки Являются постоянными обитателями кишечника
- 18. Профилактика пищевых токсикоинфекций. I. Мероприятия, направленные
- 19. II. Мероприятия, направленные на обеспечение условий, исключающих
- 20. III. Достаточная термическая обработка пищевых продуктов с
- 21. Пищевые токсикозы Пищевые токсикозы
- 22. Бактериальные токсикозы. Стафилококковый токсикоз Стафилококки очень широко
- 23. Оптимальной температурой для роста
- 24. Основным источником патогенных стафилококков является
- 25. Клиника стафилококкового токсикоза: короткий
- 26. Профилактика стафилококкового токсикоза: 1. своевременное выявление
- 27. Ботулизм тяжелое пищевое отравление, возникающее при
- 28. Споры CI. botulinum обладают
- 29. Ботулотоксин является
- 30. Профилактика ботулизма включает следующие мероприятия:быстрая переработка сырья
- 31. Микотоксикозы - алиментарные заболевания, обусловленные употреблением
- 32. Эрготизм возникает в результате употребления в пищу
- 33. К фузариотоксикозам относят ряд заболеваний человека и
- 34. Алиментарно-токсическая алейкия (септическая ангина) -
- 35. Клинические проявления заболевания: септическая ангина, геморрагическая сыпь
- 36. Отравление «пьяным хлебом» вызывается у человека и
- 37. Токсины Fusarium Graminearum обладают нейротропным действием. Заболевание
- 38. Профилактика фузариотоксикозов:1. Селекция сельскохозяйственных культур с выбором
- 39. Афлатоксикозы -заболевания, возникающие в
- 40. Токсичность афлотоксинов исключительно высока. Органом-мишенью является печень.
- 41. Пищевые отравления немикробной природы на протяжении многих
- 42. 1. отравления продуктами растительного и животного происхождения
- 43. Отравления ядовитыми грибами
- 44. К ядовитым грибам относят бледную поганку, мухоморы,
- 45. Отравления ядовитыми дикорастущими растениями чаще всего встречается
- 46. Профилактика отравлений грибами сводится к упорядочению сбора
- 47. Ядовитыми свойствами могут обладать любые части растения.
- 48. Профилактика отравлений этой группы должна быть направлена
- 49. Сорняковые токсикозы возникают при употреблении в пищу
- 50. Гелиотропный токсикоз заболевание, развивающееся при длительном употреблении
- 51. Триходесмотоксикоз– заболевание, которое возникает при использовании в
- 52. Профилактика пищевых отравлений ядовитыми семенами сорных трав
- 53. Отравления продуктами животного происхождения, ядовитыми по своей
- 54. Тетродотоксинэто один из наиболее опасных маринотоксинов. Он является метаболитом рыбы фугу.
- 55. Данный биотоксин содержится в коже, молоках, печени,
- 56. Профилактика данного вида отравлений сводится к отказу
- 57. Пищевые отравления продуктами, ядовитыми при определенных условиях,
- 58. Соланинпо своим свойствам близок к сапонинам и
- 59. Амигдалин.Горький миндаль и горькие ядра косточковых плодов
- 60. Фагинсодержится в буковых орехах. Его химическая природа
- 61. Отравления условно-съедобными грибами. К условно-съедобным грибам относятся сморчки, грузди, волнушки, чернушки, валуи и др.
- 62. СморчкиОтравления сморчками по клинической картине сходно с
- 63. Отравления продуктами животного происхождения, ядовитыми при определенных
- 64. Отравления примесями химических веществОтравления примесями химических веществ
- 65. Среди отравлений примесями химических веществ выделяют: 1.
- 66. Отравления нитратами и нитритами. Источниками пищевых
- 67. Отравления солями тяжелых металлов Большинство металлов, включая
- 68. СвинецЗаболевание сопровождается явлениями общей интоксикации (слабость, головокружение,
- 69. Соли меди и цинка В отличие от
- 70. Отравления пестицидами Пестициды представляют собой основное
- 71. Профилактика отравлений пестицидами 1. Строгий контроль за
- 72. Скачать презентанцию
Слайды и текст этой презентации
Слайд 1ПИЩЕВЫЕ ОТРАВЛЕНИЯ
Выполнил: студент П-207а группы, Сафиуллин Ильназ Ильшатович
Проверил: д.м.н. Шарафутдинов
А. Я.
Слайд 2Пищевые отравления –
это преимущественно остро протекающие заболевания,
вызываемые употреблением пищи, массивно обсемененной микробами или содержащей токсические вещества
микробной или немикробной природы.Слайд 8Пищевые отравления микробной природы -
это острые желудочно-кишечные
заболевания, возникающие при употреблении в пищу продуктов,
инфицированных условно патогенными микроорганизмами или содержащих их токсины.Слайд 9Пищевые отравления микробного происхождения имеют ряд особенностей:
часто носят массовый характер,
охватывая большие группы людей, связанных общим источником питания;
имеют короткий инкубационный
период (исчисляемый часами);не передаются от больного человека здоровому (неконтагиозны);
имеют только пищевой путь передачи.
Слайд 10По патогенезу микробные пищевые отравления разделяют на 3 группы:
Токсикоинфекции
Токсикозы
Смешанной этиологии (миксты)
Слайд 11Пищевые токсикоинфекции
(ПТИ)
ПТИ — заболевания, связанные с поступлением
в желудочно-кишечный тракт продуктов, содержащих в большом количестве живые микробы
и их токсины, выделяемые при размножении и гибели микроорганизмов.Слайд 12Для возникновения заболевания необходимы благоприятные условия:
содержание в продуктах большого числа
микробов определенных штаммов (серотипов) — свыше 103 клеток в 1г
(мл) продукта.снижение резистентности организма человека под влиянием различных болезней, нарушений питания, тяжелой физической нагрузки, интоксикаций и т.д. При этом на фоне снижения сопротивляемости организма, возникает относительное увеличение патогенности микроорганизмов.
Частыми возбудителями ПТИ являются кишечная палочка, протей, энтерококки.
Слайд 13 Широко распространена в природе, содержится в основном
в кишечнике человека, домашнего скота, птицы и др. С выделениями
из кишечника Е. coli попадает в почву, воду, на различные объекты внешней среды. Токсикоинфекции вызываются лишь энтеропатогенными серотипами.Кишечная палочка (Е. coli)
Слайд 14 На предприятиях общественного питания основным источником инфицирования продуктов
Е. coli является человек — бактерионоситель энтеропатогенных штаммов. Заболевания наиболее
часто связаны с употреблением мясных и рыбных блюд, особенно изделий из фарша, салатов, винегретов, картофельного пюре, молока, молочных продуктов и др.Слайд 15Протей (Proteus vulgaris и Proteus mirabilis)
Относится
к гнилостным бактериям и содержится в гниющих отходах. Выделяется во
внешнюю среду из кишечника человека и животных. Может длительно сохраняться и размножаться на загрязненных остатками пищи инвентаре и оборудовании.Слайд 16 На предприятия может поступать сырье и полуфабрикаты, обсемененные
протеем, а обнаружение его в готовой продукции говорит о нарушениях
правил тепловой обработки, условий хранения и сроков реализации. Чаще всего заболевания связаны с употреблением мясных продуктов, мясных салатов, рыбы и рыбных изделий, паштетов и др. Обсеменение может происходить при использовании одних и тех же разделочных досок, ножей, мясорубок для сырых и вареных продуктов.Слайд 17Энтерококки
Являются постоянными обитателями кишечника человека и животных.
Энтеротоксигенные штаммы могут находиться в верхних дыхательных путях больных ОРЗ
или бактерионосителей. Патогенные штаммы могут вызывать ПТИ при интенсивном размножении в разнообразных пищевых продуктах (изделия из фарша, заливные блюда, кремы, пудинги и др.). Энтерококки могут вызывать ослизнение продукта, неприятный горький привкус.Слайд 18Профилактика пищевых токсикоинфекций.
I. Мероприятия, направленные на предупреждение инфицирования
пищевых продуктов и пищи возбудителями ПТИ:
1. выявление
носителей условно-патогенной флоры и своевременное лечение работников, больных полибактериальными заболеваниями;2. выявление обсемененного сырья и стерилизация специй;
3. соблюдение правил механической обработки продуктов;
4. исключение контакта сырья, полуфабрикатов и готовой продукции;
5. строгое соблюдение правил личной гигиены и санитарного режима пищевого предприятия;
6. дезинфекция оборудования и инвентаря, борьба с насекомыми и грызунами.
Слайд 19II. Мероприятия, направленные на обеспечение условий, исключающих массивное размножение микроорганизмов
в продуктах:
1. хранение продуктов и готовой пищи в
условиях холода (при температуре ниже 6 °С);2. реализация готовой пищи (1-х и 2-х блюд) при температуре выше 60 °С, холодных закусок — ниже 14°С;
3. строгое соблюдение сроков реализации продукции;
4. хранение и реализация консервов в соответствии с правилами.
Слайд 20III. Достаточная термическая обработка пищевых продуктов с
целью уничтожения микроорганизмов:
1. достаточная тепловая обработка продуктов и кулинарных изделий (до достижения
80°С внутри продукта);2. обезвреживание условно годных продуктов в соответствии с правилами.
Слайд 21 Пищевые токсикозы
Пищевые токсикозы - острые заболевания,
возникающие при употреблении пищи, содержащей токсин, накопившийся в результате развития
специфического возбудителя.В эту группу заболеваний входят бактериальные токсикозы и микотоксикозы.
Слайд 22Бактериальные токсикозы.
Стафилококковый токсикоз Стафилококки очень широко распространены во внешней
среде, однако патогенными свойствами обладают лишь определенные штаммы золотистого стафилококка
(St. aureus), способные вырабатывать энтеротоксины. При размножении стафилококков и выделении энтеротоксинов органолептические свойства продуктов не изменяются.Staphylococcus
aureus
Слайд 23 Оптимальной температурой для роста стафилококков является температура
выше 22°С. При температуре ниже 4 °С и выше 45
°С их размножение прекращается. Микроорганизмы погибают при 80 °С через 20 — 30 мин. Высокая концентрация поваренной соли (>12%), сахара (>60 %) и активная кислотность (рН < 4,5) задерживает рост стафилококков. Накопление энтеротоксина наиболее активно происходит в молочных, мясных продуктах, кондитерских изделиях с кремом при температуре 28 — 37 °С.Накопившийся токсин устойчив к кислотам, щелочам и воздействию высокой температуры. Окончательное разрушение токсина происходит только при кипячении в течение 2 - 2,5 часов. Энтеротоксин не инактивируется в замороженных продуктах (мороженое).
Слайд 24 Основным источником патогенных стафилококков является человек. Стафилококки локализуются
на его кожных покровах, в носоглотке, кишечнике. Наиболее опасным источником
заражения продуктов этим возбудителем являются работники общественного питания с нагноившимися порезами, ожогами, заболеваниями верхних дыхательных путей (ангина, пневмония, отиты). Распространенным источником стафилококковой инфекции являются также животные, больные маститом или гнойными заболеваниями внутренних органов. При этом возможно заражение молока дойных или мяса убойных животных.Слайд 25 Клиника стафилококкового токсикоза: короткий инкубационный период (1-6
ч), тошнота, многократная рвота, диарея, резкие схваткообразные боли в подложечной
области, реже в области живота. Температура чаще нормальная, редко - повышенная. В тяжелых случаях резко выражены явления интоксикации. Длительность заболевания 24-48 часов. Летальные исходы наблюдаются редко.Слайд 26Профилактика стафилококкового токсикоза:
1. своевременное выявление лиц с воспалительными
заболеваниями верхних дыхательных путей и гнойничковыми поражениями кожи с последующим
отстранением их от работы с готовой пищей;2. создание условий, препятствующих образованию энтеротоксина в пищевых продуктах за счет их хранения при температуре ниже 4 °С и сокращения сроков реализации.
Роль ветеринарной службы заключается в контроле за здоровьем дойных и убойных животных. Не допускается употребление молока от больных животных в пищевых целях. Для получения различных молочных продуктов следует использовать пастеризованное молоко.
Слайд 27Ботулизм
тяжелое пищевое отравление, возникающее при употреблении пищи,
содержащей токсин CI. botulinum. Возбудитель ботулизма — спорообразующая анаэробная палочка
(CI. botulinum) обитает в кишечнике теплокровных животных, человека, птиц и рыб, обнаруживается в почве, иле водоемов, в пищевых продуктах. Известно 7 типов возбудителя (от А до G). В нашей стране большинство случаев ботулизма связано с типами А, В и Е.Слайд 28 Споры CI. botulinum обладают чрезвычайно высокой устойчивостью
к низким и высоким температурам, высушиванию, действию химических факторов.
Вегетативные формы CI. botulinum характеризуются слабой устойчивостью к высоким температурам, они погибают при 80°С в течение 15 мин. Интенсивное размножение микроорганизмов и активное токсинообразование происходят при повышенной температуре (25 - 30 °С) в строго анаэробных условиях. Причинной ботулизма чаще всего бывают консервированные продукты, а также копчености, где в глубине продукта могут создаваться анаэробные условия. Размножение CI. botulinum и накопление токсина прекращаются лишь при охлаждении продукта ниже 4°С. Накопление токсина, как правило, мало изменяет органолептические свойства продуктов, в консервах возможно развитие бомбажа (вздутие банок).
Слайд 29 Ботулотоксин является самым сильным из
всех бактериальных токсинов и отличается высокой устойчивостью к действию консервирующих
факторов.В нашей стране случаи отравлений связаны в основном с употреблением грибов домашнего консервирования, овощных и мясных консервов низкой кислотности, копченых и вяленых продуктов, изготовленных в домашних условиях. Это объясняется тем, что обеспечить необходимый режим стерилизации герметически укупоренных консервов можно только в условиях промышленного производства.
Небольшой процент случаев (2 — 3%) ботулизма во всех странах связан с консервами промышленного производства, что вызвано нарушением технологического режима их обработки.
Слайд 30Профилактика ботулизма включает следующие мероприятия:
быстрая переработка сырья и своевременное удаление
внутренностей (особенно у рыб);
тщательное мытье продуктов перед консервированием (особенно грибов
и зелени); широкое применение охлаждения и замораживания сырья и пищевых продуктов;
соблюдение режимов стерилизации консервов;
запрещение реализации консервов с признаками бомбажа или повышенным (более 2 %) уровнем брака без лабораторного анализа;
санитарная пропаганда среди населения опасности домашнего консервирования, особенно герметически укупоренных консервов из грибов, мяса и рыбы.
Слайд 31Микотоксикозы
- алиментарные заболевания, обусловленные употреблением в пищу
продуктов, содержащих микотоксины — токсины микроскопических грибов (плесеней). Микотоксины обладают
высокой токсичностью, устойчивы к действию физических и химических факторов. Многие из них обладают мутагенным, тератогенным и канцерогенным действием. Микотоксины чаще обнаруживаются в растительных продуктах, поражение которых может происходить в период созревания и уборки урожая при неблагоприятных метеорологических условиях и при неправильном хранении. К микотоксикозам относят: эрготизм, фузариотоксикозы, афлатоксикозы и др.Слайд 32Эрготизм возникает в результате употребления в пищу продуктов из зерна,
инфицированного грибами Claviceps puspurea. Токсичной для человека является покоящаяся (склероциальная)
стадия гриба, известная как «рожки спорыньи». Действующие начала спорыньи устойчивы к нагреванию и длительному хранению. Заболевание может протекать в судорожной, гангренозной и смешанной форме. При конвульсивной форме поражаются желудочно-кишечный тракт и нервная система.Характерные симптомы: слюнотечение, тошнота, рвота, колики в животе, сонливость, тонические судороги всех мышц тела, особенно сгибателей, боли в области корешков нервов. В тяжелых случаях отмечаются галлюцинации, расстройство сознания и эпилептиформные судороги.
Слайд 33К фузариотоксикозам относят ряд заболеваний человека и животных, обусловленных употреблением
продуктов, содержащих токсины грибов рода Fusarium.
Слайд 34Алиментарно-токсическая алейкия (септическая ангина)
- вызывается токсинами
грибов рода Fusarium sporotrichоideus, которые поражают ядра клеток кроветворных органов
с развитием тромбоцитопении и лейкопении вплоть до алейкии. Также снижается содержание эритроцитов (до 2×10/л). Изменения в картине крови являются первыми симптомами заболевания.Слайд 35Клинические проявления заболевания: септическая ангина, геморрагическая сыпь и подкожные кровоизлияния
на туловище и конечностях, мелкие серозно-кровянистые высыпания на слизистой оболочке
рта и языка, буллезные пузыри с серозной жидкостью на отдельных участках тела. Возможны также носовые, кишечные и маточные кровотечения. Летальность может достигать 60%.Размножению плесневых грибов этого рода способствуют поздняя уборка урожая и неудовлетворительные условия хранения: температура (12— 14 °С) и высокая относительная влажность.
Слайд 36Отравление «пьяным хлебом»
вызывается у человека и животных токсинами грибов
рода Fusarium Graminearum. Грибок поражает злаки в период роста в
поле, особенно при дождливой погоде, а также в зернохранилищах при неправильном температурном и влажностном режиме хранения.Слайд 37Токсины Fusarium Graminearum обладают нейротропным действием.
Заболевание проявляется симптомами поражения
ЦНС: возбуждение, эйфория, шаткая «пьяная» походка, головокружение, головные боли, шум
в ушах, мышечная слабость. Кроме того, наблюдается расширение зрачков, цианотичный цвет лица, явления гастроэнтерита.Все перечисленные явления исчезают на вторые сутки, оставляя после себя ощущение как бы прошедшего опьянения.
Слайд 38Профилактика фузариотоксикозов:
1. Селекция сельскохозяйственных культур с выбором устойчивых к поражению
грибками растений.
2. Использование селективных фунгицидов и биологических средств защиты растений.
3.
Строгое соблюдение установленного регламента уборки урожая.4. Строгое соблюдение установленного регламента послеуборочной обработки зерновых.
5. Охлаждение зерна после сушки до температуры не выше 15°С.
6. Удаление из продукции всех пораженных зерен.
7. Хранение зерна в водонепроницаемых хранилищах.
8. Проведение периодических проветриваний, дезинсекционных и дератизационных мероприятий.
Слайд 39Афлатоксикозы
-заболевания, возникающие в связи с
употреблением продуктов питания, зараженных афлатоксинами. Они образуются в результате жизнедеятельности
грибков, относящихся главным образом к роду Aspergillus. Данные грибки чаще встречаются в тропических и субтропических зонах, так как их рост и продукция токсина требуют определенных температурных условий и высокой влажности. Их обнаруживают на различных продуктах (зерне, арахисе, фасоли, моркови, бобах какао, а также мясе, молоке, сыре).Слайд 40Токсичность афлотоксинов исключительно высока. Органом-мишенью является печень. При острой интоксикации
развивается некроз печени и пролиферация эпителия желчных протоков. При хронической
интоксикации возникают цирроз, первичный рак печени.Профилактика афлотоксикозов во многом сходна с профилактикой фузариотоксикозов. Важно отметить, что продукты детского питания не должны содержать микотоксинов.
Слайд 41Пищевые отравления немикробной природы на протяжении многих лет занимали небольшой
удельный вес среди пищевых отравлений. На их долю приходилось не
более 1 — 2 % этих заболеваний. Вместе с тем, начиная с 90-х гг. прошлого столетия, количество немикробных отравлений начало прогрессивно расти и остается на высоком уровне. Немикробные пищевые отравления отличаются, как правило, тяжелым течением и высокой летальностью, чем и привлекают к себе внимание органов здравоохраненияПИЩЕВЫЕ ОТРАВЛЕНИЯ НЕМИКРОБНОЙ ПРИРОДЫ
Слайд 421. отравления продуктами растительного и животного происхождения ядовитыми по своей
природе;
2. отравления продуктами растительного и животного происхождения, ядовитыми при
определенных условиях;3. отравления примесями химической природы.
Все пищевые отравления немикробной природы можно разделить на три группы
Слайд 44К ядовитым грибам относят бледную поганку, мухоморы, сатанинский гриб, строчки
и др. Основной причиной отравлений ядовитыми грибами, по мнению специалистов,
является их ошибочный сбор.Слайд 45Отравления ядовитыми дикорастущими растениями чаще всего встречается среди детей при
ошибочном употреблении их в пищу вместо съедобных. Такие отравления, как
правило, носят случайный характер и происходят во время прогулок.Отравления дикорастущими ядовитыми растениями
Слайд 46Профилактика отравлений грибами сводится к упорядочению сбора грибов, их переработки
и реализации. Собирать можно только заведомо съедобные грибы. На заготовительных
пунктах от сборщиков необходимо принимать только сортированные грибы. Переработку грибов и изготовление грибных полуфабрикатов на предприятиях агропромышленных комплексов следует проводить по утвержденным стандартам и правилам.Профилактика
Слайд 47Ядовитыми свойствами могут обладать любые части растения. Для данной группы
отравлений характерен очень короткий инкубационный период (от 15-20 минут до
1часа) и очень высокая летальность (смерть может наступить через 1,5 — 3 ч, причем чаще всего от паралича дыхания). Симптоматика зависит от действующего начала растения.Слайд 48Профилактика отравлений этой группы должна быть направлена на ограждение детей
от возможности поедания ядовитых растений. Для этого рекомендуется регулярно (2
— 3 раза в неделю) проводить осмотр земельных участков детских учреждений и мест постоянных прогулок детей. При обнаружении ядовитых растений проводится очистка участка (скашивание или выдергивание растений с последующим их уничтожением), перекапывание почвы и др.Слайд 49Сорняковые токсикозы
возникают при употреблении в пищу изделий из зерна,
зараженного ядовитыми семенами некоторых сорных растений. При этом наблюдаются тяжелые
хронические отравления.Слайд 50Гелиотропный токсикоз
заболевание, развивающееся при длительном употреблении в пищу изделий
из зерна, засоренного семенами гелиотропа опушенноплодного. Гелиотропный токсикоз развивается медленно
и имеет признаки токсического гепатита: увеличение печени, желтуха, асцит. Смертность в тяжелых случаях достигает 20-30%.Слайд 51Триходесмотоксикоз
– заболевание, которое возникает при использовании в питании изделий из
зерна, засоренного семенами седой триходесмы. Клиническая картина включает в себя
симптомы энцефалита и менингоэнцефалита. Наблюдаются общая слабость, разбитость, боли в мышцах, головная боль, головокружение, тошнота, рвота. Иногда наблюдается внезапная потеря речи, отнимаются руки и ноги, часто наблюдаются эпилептиформные припадки. Резко понижается артериальное давление (до 55 и 80 мм рт. ст.) Тяжелые формы отравления приводят к летальным исходам в 35% случаев.Слайд 52Профилактика пищевых отравлений ядовитыми семенами сорных трав заключается в тщательной
очистке семенного зерна, своевременной прополке посевов от сорных трав, ранней
и быстрой уборке посевов, так как сорные травы созревают в более поздние сроки, запрещение для использования с пищевой целью дробленого зерна, использование современных гербицидов.Слайд 53Отравления продуктами животного происхождения, ядовитыми по своей природе
Отравления ядовитыми животными
тканями встречаются достаточно редк. Они связаны с употреблением в пищу
ядовитых тканей рыб (маринка, фугу, иглобрюх, усач, севанский хромуль), моллюсков и желез внутренней секреции убойных животных, содержащих токсичные природные соединения. Биотоксины чаще концентрируются в отдельных органах и тканях ядовитых рыб (молоки, икра, кожа, брюшина, печень), реже – равномерно распределяются в толще мышц.Слайд 54Тетродотоксин
это один из наиболее опасных маринотоксинов. Он является метаболитом рыбы
фугу.
Слайд 55Данный биотоксин содержится в коже, молоках, печени, икре и внутренностях
рыбы. В мышечной ткани тетродотоксин не накапливается.
Слайд 56Профилактика данного вида отравлений сводится к отказу от употребления в
пищу поджелудочной железы и надпочечников убойного скота, а также ядовитых
видов рыб и моллюсков, особенно если они выловлены в тропических и экваториальных моряхСлайд 57Пищевые отравления продуктами, ядовитыми при определенных условиях, встречаются очень редко.
В эту группу входят отравления продуктами растительного и животного происхождения.
Из растительных продуктов это фазин сырой фасоли, амигдалин ядер косточковых плодов, фагин буковых орехов, соланин картофеля, а также отравления условно-съедобными грибами. Из продуктов животного происхождения к ним относятся ткани рыб, мидии, пчелиный мед.Отравления растительными продуктами, ядовитыми при определенных условиях.
Слайд 58Соланин
по своим свойствам близок к сапонинам и гликозидам и является
гемолитическим ядом. Соланин содержится в картофеле в небольших количествах (2
- 11 мг%), в основном в кожуре. При неправильном хранении картофеля (на открытом воздухе и при высоком уровне освещения) происходит его позеленение и прорастание, сопровождающиеся резким повышением содержания соланина (до 73 мг %). Отравления аозникают при приготовлении пюре из такого картофеля (без удаления отвара, в котором варился картофель) или при употреблении картофеля, сваренного с кожурой. При этом отмечается горьковатый вкус и царапающее ощущение в глотке, затем появляются тошнота, рвота, понос. Отравления соланином картофеля редки, так как обычно основные его количества удаляются с кожурой.Слайд 59Амигдалин.
Горький миндаль и горькие ядра косточковых плодов (вишня, персики, абрикосы)
содержат гликозид амигдалин, который при гидролизе отщепляет синильную кислоту.
В
легких случаях отравление проявляется головной болью и тошнотой. В тяжелых случаях наблюдаются цианоз, судороги, потеря сознания. Слайд 60Фагин
содержится в буковых орехах. Его химическая природа не выяснена. Отравления
сырыми буковыми орехами проявляются ухудшением самочувствия, головной болью, тошнотой, дисфункцией
кишечника. Отравления вызывают только сырые орехи, так как под влиянием термической обработки фагин быстро инактивируется.Слайд 61Отравления условно-съедобными грибами.
К условно-съедобным грибам относятся сморчки, грузди, волнушки,
чернушки, валуи и др.
Слайд 62Сморчки
Отравления сморчками по клинической картине сходно с отравлением, вызываемым строчками,
но протекает обычно легче. Ядовитым началом сморчков является гельвелловая кислота
(но не гиромитрин как у строчков). Гельвелловая кислота, при отваривании грибов переходит в бульон. В связи с этим, отравления, как правило, обусловлены употреблением грибов в жареном виде без предварительного отваривания с удалением бульона. Для того, чтобы предотвратить отравление сморчками, грибы надо прокипятить дважды. Длительность каждого кипячения - 20 - 30 минут. Воду после кипячения следует слить.Слайд 63Отравления продуктами животного происхождения, ядовитыми при определенных условиях.
Отравления тканями рыб.
Эти отравления наблюдаются преимущественно при употреблении икры, молок и печени
некоторых видов рыб (налима, щуки, окуня, скумбрии и др.), приобретающих токсические свойства в период нереста. Отравления протекают по типу острого гастроэнтерита.Слайд 64Отравления примесями химических веществ
Отравления примесями химических веществ могут быть связаны
с их включением в пищевую цепочку и накоплением в продуктах
питания в качестве чужеродных веществ. Данный вид отравлений также может быть обусловлен миграцией в пищу химических веществ из оборудования, инвентаря, тары и упаковочных материалов в процессе переработки продуктов и приготовления пищи.Слайд 65Среди отравлений примесями химических веществ выделяют:
1. Отравления нитратами, нитритами.
2. Отравления
солями тяжелых металлов
3. Отравления пестицидами.
4. Отравления пищевыми добавками.
Слайд 66Отравления нитратами и нитритами.
Источниками пищевых нитратов являются преимущественно продукты
растениеводства, особенно зелень и корнеплоды.
Допустимая суточная доза (ДСД) для нитратов
(пища + вода) 5 мг/кг массы тела. Для нитритов – 0,15 мг/кг массы тела в расчете на ион нитрита или 0,2 мг/кг массы тела – нитрита натрия.Снижение до минимума содержания в пищевых рационах населения нитратов и нитритов является актуальной задачей
Слайд 67Отравления солями тяжелых металлов
Большинство металлов, включая тяжелые, являются эссенциальными факторами
для организма человека. Однако в определенных концентрациях ряд из них
представляет опасность для здоровья.Слайд 68Свинец
Заболевание сопровождается явлениями общей интоксикации (слабость, головокружение, головная боль, неприятный
вкус во рту). Из специфических явлений – тремор конечностей, потеря
массы тела, голубовато-серая «свинцовая» кайма на деснах, свинцовые колики, запоры, анемии. Характерным признаком хронического отравления свинцом служит серая окраска кожи – свинцовый колорит. Также отмечаются нарушения со стороны нервной системы в виде парезов, параличей и судорог.Основным источником свинца в продуктах является посуда для приготовления пищи с покрытиями, содержащими свинец (полуда, глазурь, эмаль), в которых содержание свинца превышает допустимые нормы. Чаще всего это жестяные металлические консервы, в которых свинец переходит в продукты из оловянного покрытия жести и свинцового припоя в швах банки, а также глазурованная керамическая посуда кустарного изготовления.
Слайд 69Соли меди и цинка
В отличие от соединений свинца соли меди
и цинка вызывают только острые отравления. Такие отравления возникают при
неправильном использовании медной и оцинкованной посуды. Через 2-3 часа после употребления пищи, содержащей соли меди, у больных появляются коликообразные боли в животе, кровавый понос, рвота сине-зелеными массами, наличие медного вкуса во рту, головная боль и слабость. Заболевание заканчивается в течение первых суток. Профилактика отравлений медью основана на отказе от использования нелуженой (оловом) медной посуды в быту.Слайд 70Отравления пестицидами
Пестициды представляют собой основное ядро чужеродных химических веществ,
поступающих в организм человека алиментарным путем. Наиболее распространены хлорорганические, фосфорорганические,
ртутьорганические пестициды и карбоматы. Особую опасность представляют пестициды, характеризующиеся высокой устойчивостью во внешней среде, выраженными кумулятивными свойствами и способностью выделяться с молоком кормящих матерей и лактирующих животных. К этой группе относятся хлорорганические пестициды.Слайд 71Профилактика отравлений пестицидами
1. Строгий контроль за производством, транспортировкой, хранением
и применением ядохимикатов.
2. Строгое соблюдение агротехнических приемов использования пестицидов
с учетом их токсикологических характеристик.3. Контроль содержания остаточных количеств пестицидов в пищевых продуктах. Использование продуктов с содержанием остаточных количеств пестицидов, превышающих максимально допустимые уровни, запрещается.
4. Разработка специальных методов освобождения пищевых продуктов от остатков пестицидов. Так, установлено, что наиболее эффективными методами освобождения молока от остатков пестицидов являются его обезжиривание и сушка, позволяющие почти полностью удалить стойкие пестициды из продукта.